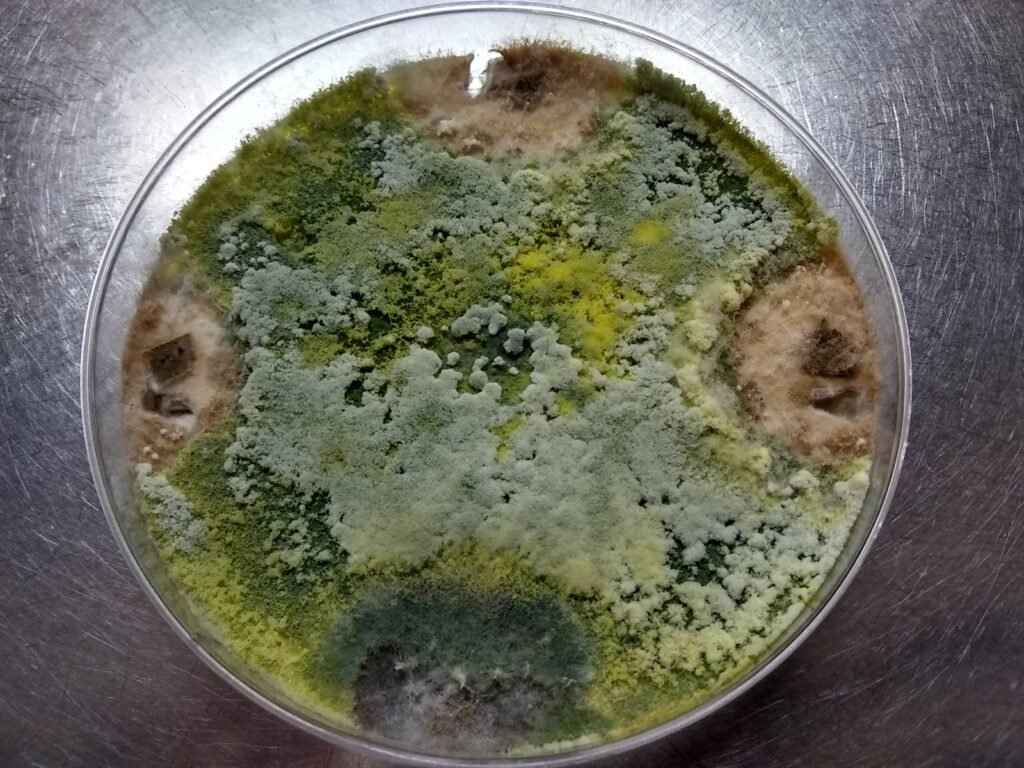

Serviços Oferecidos
Por que nos escolher?

Assessoria técnica

Diagnose de doenças e identificação de pragas agrícolas e florestais

Monitoramento e manejo integrado de doenças e pragas

Testagem da eficácia de produtos químicos e biológicos
Bioprospecção de microrganismos com potencial agrícola e biotecnológico
Diagnose de doenças e identificação de pragas agrícolas e florestais

A diagnose de doenças e identificação de pragas é um processo essencial na agricultura e na proteção de cultivos, que envolve a análise e reconhecimento de organismos que podem causar danos às plantas
Testes da eficácia de produtos
Os testes de produtos envolvem as avaliações para a eficiência de uma formulação destinada a proteção de cultivos. Esses testes são essenciais para garantir que os produtos utilizados na agricultura sejam seguros, eficazes e atendam aos padrões regulatórios.

Assessoria técnica e treinamentos

Oferecemos acessoria técnica e treinamentos customizados, de forma presencial ou virtual, abordando temas relacionados a fitossanidade.
Para maiores informações entre em contato conosco.
